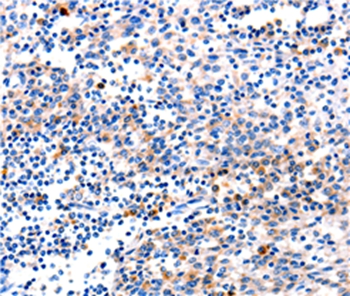
Anti-GADD45G Antibody

GADD45G antibody [C1C3]
GTX108257
ApplicationsImmunoFluorescence, Western Blot, ImmunoCytoChemistry
Product group Antibodies
TargetGADD45G
Overview
- SupplierGeneTex
- Product NameGADD45G antibody [C1C3]
- Delivery Days Customer9
- Application Supplier NoteWB: 1:500-1:3000. ICC/IF: 1:100-1:1000. *Optimal dilutions/concentrations should be determined by the researcher.Not tested in other applications.
- ApplicationsImmunoFluorescence, Western Blot, ImmunoCytoChemistry
- CertificationResearch Use Only
- ClonalityPolyclonal
- Concentration1 mg/ml
- ConjugateUnconjugated
- Gene ID10912
- Target nameGADD45G
- Target descriptiongrowth arrest and DNA damage inducible gamma
- Target synonymsCR6, DDIT2, GADD45gamma, GRP17, growth arrest and DNA damage-inducible protein GADD45 gamma, DDIT-2, DNA damage-inducible transcript 2 protein, GADD45-gamma, cytokine-responsive protein CR6, gadd-related protein, 17 kD
- HostRabbit
- IsotypeIgG
- Protein IDO95257
- Protein NameGrowth arrest and DNA damage-inducible protein GADD45 gamma
- Scientific DescriptionThis gene is a member of a group of genes whose transcript levels are increased following stressful growth arrest conditions and treatment with DNA-damaging agents. The protein encoded by this gene responds to environmental stresses by mediating activation of the p38/JNK pathway via MTK1/MEKK4 kinase. The GADD45G is highly expressed in placenta. [provided by RefSeq]
- Storage Instruction-20°C or -80°C,2°C to 8°C
- UNSPSC12352203